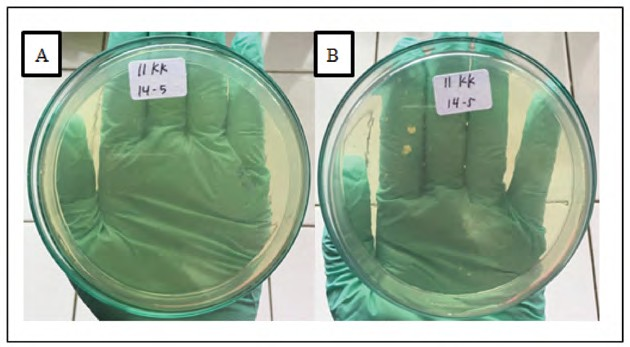

Familial Erythema Annulare Centrifugum pada Anak Berusia 9 Tahun
Achmad Satya Negara, Endra Yustin Ellista Sari
Achmad Satya Negara, Endra Yustin Ellista Sari

Familial Erythema Annulare Centrifugum pada Anak Berusia 9 Tahun
Sumber: Medicinus Edisi Desember 2021 Volume 34, Issue 3
Achmad Satya Negara, Endra Yustin Elistasari
Bagian/KSM Ilmu Kesehatan Kulit dan Kelamin
Fakultas Kedokteran Universitas Sebelas Maret/RSUD Dr. Moewardi, Surakarta
Latar belakang: Erythema annulare centrifugum (EAC) merupakan penyakit kulit langka yang ditandai oleh papul merah muda erupsi yang meluas secara sentrifugal, membentuk plak anular atau polisiklik dengan central clearing, dengan lokasi predileksi pada ekstremitas inferior dan trunkus. Etiologi EAC masih belum diketahui secara pasti, namun diperkirakan berkaitan dengan riwayat konsumsi obat tertentu, infeksi, keganasan, atau stress. Diagnosis EAC ditegakkan berdasarkan manifestasi klinis dan pemeriksaan histopatologi. Secara histopatologi, EAC dapat dibedakan menjadi 2 bentuk, yaitu superfisial dan profunda. Tanda patognomonik dari histopatologi EAC berupa gambaran coat sleeve dan trailing scale. Tata laksana simtomatik EAC dapat dilakukan dengan pemberian corticosteroid topikal, analog vitamin D, dan antihistamine. Laporan kasus ini bertujuan untuk memberi gambaran penegakan diagnosis EAC. Kasus: Seorang anak laki-laki berusia 9 tahun datang dengan keluhan bercak kemerahan di wajah dan badan. Pemeriksaan biopsi histopatologi menunjukkan gambaran hiperkeratosis dan spongiosis ringan pada lapisan epidermis serta infiltrat limfositik perivaskular pada lapisan dermis. Dari hasil pemeriksaan fisik dan histopatologi, pasien didiagnosis dengan erythema annulare centrifugum. Pasien diberikan terapi menggunakan antihistamine dan corticosteroid topikal. Diskusi: Erythema annulare centrifugum (EAC) merupakan kelainan kulit yang jarang dijumpai, di mana sebagian besar kasus bersifat idiopatik. Pemeriksaan biopsi histopatologi merupakan pemeriksaan yang dapat digunakan untuk membantu penegakan diagnosis EAC. Pada kasus EAC idiopatik, pemberian terapi corticosteroid topikal maupun sistemik menjadi pilihan utama, namun terapi empiris menggunakan antibiotik atau antijamur topikal mungkin dapat dipertimbangkan.
Kata kunci: erythema annulare centrifugum, idiopatik, central clearing, histopatologi
Abstract
Background: Erythema annulare centrifugum (EAC) is a rare cutaneous disease characterized by erythematous papule which slowly migrates and peripherally enlarges into polycyclic lesion with central clearing that usually involves thigh and legs area. The etiology is unclear, but presumabley related with medication history, infection, malignancy, and stress. The diagnosis of EAC is based on clinical manifestations and histopathological examination. Histopathologically, EAC can be divided into superficial and deep type. Pathognomonic signs include coat sleeve and trailing scale. Symptomatic treatment of EAC may involve topical corticosteroid, topical vitamin D analog, and antihistamine. Case: A 9-year-old boy came with a complaint of erythematous patches on his face and body. Histopathological biopsy showed showed a mild appearance of hyperkeratosis and spongiosis at the epidermis, and perivascular lymphocytic infiltrate at the dermis. Based on these findings, patient was diagnosed with erythema annulare centrifugum. We gave antihistamine and topical corticosteroid to treat his condition. Discussion: Erythema annular centrifugum is a rare skin condition, with most cases is idiopathic. Histopathological biopsy can be used to help establish the diagnosis of EAC. Topical & systemic corticosteroid is the first-line therapy of idiopathic EAC, but administration of empirical therapy using antibiotics or antifungals may also be considered.
Keywords: erythema annulare centrifugum, idiopathic, central clearing, histopathological
PENDAHULUAN
Erythema annulare centrifugum (EAC) merupakan penyakit kulit langka yang ditandai oleh plak anular dengan central clearing, yang disertai rasa gatal atau terkadang asimtomatik dengan durasi bervariasi dan biasanya melibatkan paha dan kaki.1 Istilah EAC sebelumnya digunakan oleh Darier pada tahun 1916 untuk menggambarkan plak anular atau polisiklik eritem yang membesar secara sentrifugal. Penyakit ini termasuk penyakit yang jarang ditemukan sehingga data epidemiologi sangat jarang dilaporkan.2 Prevalensi EAC diperkirakan sebesar 1 kasus per 100.000 penduduk di seluruh dunia setiap tahunnya.3 Penyakit EAC dapat ditemukan pada semua kelompok usia dan tidak terdapat perbedaan prevalensi menurut jenis kelamin.4
Hingga saat ini, etiologi EAS masih belum diketahui secara pasti, dan sebagian besar merupakan kasus idiopatik, namun diperkirakan kelainan kulit ini berkaitan dengan riwayat pengobatan (misalnya diuretik, obat antiinflamasi nonsteroid, antimalaria, finasteride, amitriptillin, etizolam, azacitide, ribavirin, rituximab), infeksi, keganasan, dan stress.5 Infeksi yang berhubungan dengan kejadian EAC antara lain dapat disebabkan oleh jamur (Candida spp., Penicillium spp.), virus (poxvirus, Epstein-Barr virus, varicella-zoster virus, human immunodeficiency virus), serta parasit dan ektoparasit (misalnya Phthirus pubis).4 Hepatitis autoimun dan lupus eritematosus sistemik (LES) merupakan penyakit yang dapat mendasari terjadinya erupsi EAC.1,2 Patogenesis EAC diperkirakan terjadi melalui reaksi hipersensitivitas tipe IV yang diperantarai oleh T-helper 1 (Th1) yang berhubungan dengan peningkatan kadar tumor necrosis factor alpha (TNF-α) dan cytokine interleukin-2 (IL-2).4,5,6
Gejala EAC seringkali asimtomatik, meskipun terkadang pasien juga mengeluh gatal.2 Wujud kelainan kulit pada EAC berupa papul merah muda yang meluas secara sentrifugal, membentuk plak anular atau polisiklik dengan central clearing. Lesi EAC superfisial menunjukkan deskuamasi bersisik berbatas tegas atau disebut dengan trailing scale, sementara lesi EAC profunda tidak bersisik namun mempunyai batas yang tegas.7 Predileksi lokasi terutama ditemukan pada ekstremitas inferior dan trunkus, sedangkan keterlibatan ekstremitas superior, kepala dan leher jarang dilaporkan.2 Lesi EAC dapat bertahan dalam hitungan minggu hingga beberapa tahun dan dapat menghilang dengan sendirinya.7 Pada sebagian besar kasus EAC, pasien tidak mempunyai riwayat penyakit yang mendasarinya serta kasus yang dilaporkan tidak mempunyai onset, fluktuasi atau durasi yang spesifik.3
Diagnosis EAC ditegakkan berdasarkan manifestasi klinis dan pemeriksaan histopatologi. Pemeriksaan laboratorium lainnya tidak memiliki peran khusus dalam penegakkan diagnosis EAC. Pemeriksaan histopatologi merupakan baku emas penegakan diagnosis EAC, terutama untuk dapat membedakan EAC dengan penyakit lain yang mempunyai lesi anular.2,4 Secara histopatologi, berdasarkan perluasan infiltrasi limfosit perivaskular, EAC dapat dibedakan menjadi 2 bentuk yang berbeda, yaitu EAS superfisial dan profunda (deep).8 Pemeriksaaan histopatologi EAC superfisial menunjukkan gambaran spongiosis epidermal yang mewakili pola reaksi hipersensitivitas.4 Tanda patognomonik pemeriksaan histopatologi EAC superfisial berupa spongiosis fokal, parakeratosis dan infiltrat limfohistiosit perivaskular yang membentuk coat sleeve di sekitar pleksus vaskular superfisial, sementara pada EAC profunda, coat sleeve terdapat pada pleksus vaskular superfisial dan profunda serta tidak menunjukkan perubahan epidermis.7
Penatalaksanaan EAC simtomatik dapat menggunakan corticosteroid topikal, analog vitamin D, dan antihistamine. Pada kasus EAC yang disebabkan oleh penyakit yang mendasarinya, lesi kulit akan sembuh setelah penyakit yang mendasarinya berhasil diobati. Sebagian kasus EAC dapat sembuh dengan sendirinya, namun beberapa kasus EAC lainnya diketahui resistan terhadap terapi.2,4 Berdasarkan uraian tersebut tujuan dari penyusunan laporan kasus ini adalah untuk mendeskripsikan proses penegakan diagnosis erythema annulare centrifugum sehingga dapat diberikan tata laksana yang tepat.
KASUS
Pasien An.A, pelajar berusia 9 tahun yang berdomisili di Sukoharjo, datang ke bagian Poliklinik Kulit dan Kelamin RSUD Dr. Moewardi (RSDM) Surakarta dengan keluhan utama muncul plak kemerahan pada wajah dan badan. Berdasarkan hasil aloanamnesis, pasien mengeluh saat memasuki sekolah pada usia 7 tahun muncul bentol kemerahan di badan yang lama kelamaan semakin banyak, lalu menyatu membentuk bercak kemerahan bersisik yang menyebar hingga wajah dan anggota gerak. Pasien pernah mengalami sakit kulit serupa sebelumnya pada saat lahir, pertama kali muncul di badan. Keluhan tersebut dirasakan hilang timbul hingga saat ini, dan sempat membaik setelah mendapat krim racikan dari dokter. Keluhan pasien dirasakan bertambah berat dan tidak menunjukkan perbaikan walaupun telah berobat ke dokter spesialis kulit sejak 1 bulan yang lalu. Keluhan rasa gatal dirasakan bertambah berat saat pasien berkeringat dan melakukan banyak aktivitas di bawah sinar matahari. Karena kondisinya tidak menunjukkan perbaikan, keluarga pasien memutuskan untuk membawa pasien berobat ke Poliklinik Kulit dan Kelamin RSDM Surakarta untuk pemeriksaan lebih lanjut.
Pasien merupakan anak kedua dari dua bersaudara. Pasien lahir saat usia kehamilan 40 minggu secara normal, dibantu oleh bidan dengan berat badan lahir 3.800 gram dan panjang badan 50 cm. Riwayat imunisasi pasien lengkap sesuai usia. Riwayat alergi makanan, obat maupun cuaca disangkal. Pasien dan ibu pasien memiliki riwayat sering bersin pada pagi hari. Riwayat asma dan eksim disangkal. Ibu pasien mengaku selama kehamilan anak kedua pernah mengalami keluhan serupa dengan pasien yaitu muncul bercak kemerahan di badan yang terasa gatal pada saat memasuki usia kehamilan 5 bulan. Keluhan ibu pasien tersebut dirasakan mulai menghilang pada saat melahirkan anaknya. Nenek dan kakak pasien juga diketahui menderita penyakit serupa (Gambar 1).

Gambar 1. Pohon keluarga pasien
Hasil pemeriksaan fisik didapatkan keadaan umum pasien kesadaran compos mentis dengan berat badan 30 kg, tinggi badan 150 cm, dan status gizi cukup. Tanda vital pasien dalam batas normal. Status dermatologi pada regio fasialis et trunkus anterior et posterior et ekstremitas superior et inferior tampak plak eritem multipel dengan sebagian lesi central clearing disertai skuama di atasnya (Gambar 2). Berdasarkan anamnesis dan pemeriksaan fisik, pasien kami diagnosis banding dengan EAC, tinea corporis, dan pityriasis alba.

Gambar 2. (A-I) Regio fasialis et trunkus anterior et posterior et ekstremitas superior et inferior tampak plak eritem multipel dengan central clearing disertai skuama di atasnya (panah biru).
Pemeriksaan penunjang berupa lampu Wood, kerokan kulit pada tepi lesi kulit dengan potassium hydroxide (KOH) 10% dan kultur jamur dilakukan untuk menyingkirkan diagnosis banding. Pada hasil pemeriksaan lampu Wood pada area lesi tidak didapatkan fluoresensi kehijauan. Pada pemeriksaan kerokan kulit pada lesi di area perut dan punggung dengan KOH 10% tidak ditemukan spora atau hifa. Pada pemeriksaan kultur jamur tidak ditemukan adanya pertumbuhan jamur, namun ditemukan pertumbuhan koloni bakteri (Gambar 3). Pemeriksaan penunjang khusus untuk pityriasis alba tidak dibutuhkan, akan tetapi dapat dilakukan pemeriksaan lampu Wood untuk memperjelas lesi dan histopatologi apabila diagnosis meragukan. Pemeriksaan biopsi histopatologi dilakukan untuk menegakkan diagnosis EAC. Sediaan mikroskopis diambil dari jaringan kulit wajah yang diwarnai dengan hematoxylin dan eosin (HE). Gambaran histopatologi menunjukkan pada lapisan epidermis tampak gambaran hiperkeratosis dan spongiosis ringan serta infiltrat limfosit perivaskular di sekitar pembuluh darah (coat sleeve) pada lapisan dermis (Gambar 4). Berdasarkan hasil anamnesis, pemeriksaan fisik, pemeriksaan laboratorium, dan histopatologi pasien kami diagnosis kerja dengan erythema annulare centrifugum (EAC).
Gambar 3. (A-B) Hasil pemeriksaan kultur jamur tidak menunjukkan adanya pertumbuhan jamur, namun ditemukan koloni bakteri.

Gambar 4. (A-B) Pada lapisan epidermis tampak hiperkeratosis (panah kuning) dan spongiosis ringan (panah hijau) (HE, 40x) (C) Pada lapisan dermis tampak infiltrat limfosit perivaskular di sekitar pembuluh darah (coat sleeve) (panah biru) (HE, 40x).
Kami memberikan terapi menggunakan cetirizine 1x10 mg sesuai usia dan berat badan pasien serta krim mometasone 0,1% yang dioleskan sehari dua kali sambil menunggu hasil biopsi. Pasien diedukasi untuk menghindari faktor pencetus seperti aktivitas berlebih dan paparan sinar matahari langsung, serta selalu memakai losion atopiclair sesaat setelah mandi. Satu minggu pertama setelah pemberian terapi tampak perbaikan klinis yang cukup bermakna dengan berkurangnya lesi eritematosa terutama di area wajah dan badan. Enam minggu kemudian pasien kembali kontrol ke poli, lesi kulit tampak semakin berkurang, kemerahan menghilang disertai rasa gatal yang berkurang (Gambar 5).

Gambar 5. (A-C) Pada regio fasialis et trunkus anterior et posterior et ekstremitas superior tampak plak eritem multipel dengan central clearing disertai skuama di atasnya. (D-F) Satu minggu pertama setelah pemberian terapi pasien menunjukkan perbaikan klinis yang cukup bermakna dengan berkurangnya lesi eritematosa terutama di regio fasialis. (G-I) Enam minggu kemudian lesi kulit semakin berkurang, kemerahan menghilang, disertai rasa gatal yang berkurang.
PEMBAHASAN
Erythema annulare centrifugum (EAC) merupakan penyakit kulit yang jarang ditemukan dan ditandai dengan plak eritem anular persisten disertai central clearing.9 Erythema annulare centrifugum dapat ditemukan pada semua kelompok usia dengan insidensi puncak pada dekade kelima kehidupan dan tidak terdapat perbedaan prevalensi berdasarkan jenis kelamin.2,4 Data epidemiologi EAC jarang dilaporkan. Penelitian oleh Kim, dkk. (2002) melaporkan 66 kasus EAC di Korea pada tahun 1990-2000 yang terdiri dari 24 orang laki-laki dan 42 perempuan dengan onset usia bervariasi antara 5-71 tahun.10 Kasus EAC pada anak-anak sangat jarang dilaporkan. Kruse dkk. (2016) melaporkan kasus EAC kronis residif pada 5 orang anak dengan rentang usia 5 bulan sampai 3 tahun, di mana durasi rata-rata penyakit adalah 17 bulan.9 Pada kasus ini, EAC terjadi pada anak laki-laki berusia 9 tahun dengan onset awal saat lahir.
Etiologi pasti EAC belum diketahui secara pasti, dan sebagian besar kasus bersifat idiopatik. Walaupun demikian, beberapa faktor telah diketahui dapat memicu terjadinya EAC, antara lain reaksi hipersensitivitas terhadap pengobatan (amitriptyline, hydroxychloroquine, cymetidine, nonsteroid antiinflammatory drugs, finasteride, etizolam), makanan (blue cheese), penyakit autoimun (Graves’ disease, sindrom hipereosinofilik, progesterone dermatitis), stres psikologis, atau kehamilan. Erythema annulare centrifugum juga telah dilaporkan berhubungan dengan pedikulosis, molluscum contagiosum, herpes zoster, infeksi Malassezia spp., dermatofita, atau Candida spp.9,11 Pasien pada kasus ini tidak mempunyai riwayat obat-obatan yang dikonsumsi sebelumnya, dan tidak mempunyai riwayat menderita infeksi dan penyakit yang diketahui dapat memicu EAC, sehingga diduga EAC pada pasien ini berhubungan dengan faktor keturunan atau stres psikologis.4,5
Erythema annulare centrifugum (EAC) pernah dilaporkan sebagai kasus familial dominan autosomal pada 4 anggota keluarga dari tiga generasi dalam sebuah keluarga di Irlandia. Penelitian lainnya oleh Williams, dkk. (2011) melaporkan terjadinya EAC familial dominan autosomal pada anak berusia 5 hari dengan keluhan plak eritema anular di seluruh tubuh, di mana ibu pasien juga mempunyai keluhan serupa.12 Penelitian lainnya oleh Carlesimo, dkk. (2013) melaporkan kasus EAC yang terjadi pada tiga generasi dalam sebuah keluarga yaitu ibu, saudara kandung, dan keponakan pasien yang mengarah pada hipotesis bahwa EAC merupakan penyakit yang diturunkan secara dominan autosomal. Pada kasus ini, nenek, ibu, dan kakak pasien juga mengalami keluhan yang sama dengan pasien yaitu muncul plak anular kemerahan di badan disertai rasa gatal. Berdasarkan uraian tersebut, pada kemungkinan dari kasus ini terdapat keterlibatan faktor familial dominan autosomal walaupun belum dibuktikan secara genetika. Nenek pasien mengalami keluhan serupa pasien sejak usia 40 tahun secara tiba-tiba dan hingga sekarang keluhan tersebut masih dirasakan hilang timbul meskipun telah berobat. Ibu pasien diketahui mulai merasakan keluhan yang sserupa pada saat hamil dan sembuh sesudah melahirkan, sedangkan kakak pasien mulai muncul saat lahir dan hilang timbul hingga sekarang. Hubungan antara faktor genetika terhadap erupsi kulit EAC hingga saat ini masih belum diketahui secara pasti.13 Faktor stres psikologis yang berkaitan dengan kegiatan belajar di sekolah juga diperkirakan menjadi salah satu pencetus EAC. Penelitian oleh Valizadeh, dkk. (2012) melaporkan lebih dari 400 orang anak sekolah dasar mengalami stres psikologis.14 Pada kasus ini, tidak dilakukan penilaian tolak ukur stres psikologis pada pasien, namun dari hasil anamnesis anak mengeluhkan bahwa plak bertambah sejak mulai bersekolah. Faktor stres tersebut dapat memicu eksaserbasi penderita EAC.15 Fotosensitivitas juga merupakan salah satu faktor risiko yang diperkirakan berpengaruh terhadap munculnya lesi EAC. Penelitian menunjukkan bahwa lesi EAC sering muncul pada musim semi atau musim panas dan mengalami kesembuhan dengan sendirinya setelah beberapa hari hingga berbulan- bulan.1 Pasien pada kasus ini juga mengaku plak bertambah banyak dan bertambah lebar saat banyak melakukan aktivitas di bawah sinar matahari terutama saat musim kemarau.
Patogenesis EAC hingga saat ini diperkirakan merupakan bagian dari reaksi hipersensitivitas tipe IV yang dimediasi oleh T-helper 1 (Th1) serta berhubungan dengan peningkatan kadar tumor necrosis factor alpha (TNF-α) dan cytokine interleukin-2 (IL-2).2,6 Penelitian oleh Sarro (2005) menunjukkan terjadi peningkatan TNF-α pada beberapa kasus EAC, sehingga terdapat kemungkinan EAC merupakan penyakit yang dimediasi oleh Th1, namun hal ini memerlukan penelitian lebih lanjut.16
Lesi EAC umumnya asimtomatik atau terkadang dapat disertai dengan rasa gatal ringan. Gejala dapat kambuh dalam waktu berbulan-bulan hingga bertahun-tahun bergantung pada proses etiologi yang mendasarinya.17 Lesi EAC pertama kali muncul sebagai papul kemerahan tunggal atau multipel yang meluas ke perifer dengan lambat sekitar 1-3 mm/hari hingga 4 cm dalam seminggu. Lesi baru EAC mungkin terbentuk dalam lesi EAC primer yang menyebabkan wujud kelainan kulit EAC menjadi irregular, oval, semiannular, berbentuk seperti target, atau polisiklik.18 Lokasi predileksi terbanyak EAC adalah trunkus dan ekstremitas inferior, serta jarang dilaporkan pada ekstremitas superior, wajah, dan leher.2 Penelitian Mandel, dkk. (2015) melaporkan kasus EAC pada wanita di mana pertama kali muncul papul eritem kecil yang kemudian bertambah banyak dan menyatu membentuk plak anular dengan central clearing. Beberapa lesi mempunyai batas bersisik dan pasien mengeluhkan rasa gatal.1 Pasien pada kasus ini pertama kali mengeluhkan munculnya bentol kemerahan yang semakin banyak menyatu lalu membentuk bercak kemerahan bersisik di badan yang kemudian menyebar ke anggota gerak dan wajah. Pasien tidak mengeluhkan adanya gejala lain selain rasa gatal ringan.
Pasien kami diagnosis banding dengan EAC, tinea corporis berdasarkan pemeriksaan fisik ujud kelainan kulit (UKK). Tinea corporis merupakan infeksi jamur superfisial yang disebabkan oleh genus Microsporum, Tricophyton dan Epidermophyton.19 Gejala klinis tinea corporis berupa plak anular eritematosa dengan tepi meninggi yang terasa gatal terutama ketika keadaan lembap atau keringat berlebih. Lesi kulit tinea corporis dapat berupa lesi tunggal atau multipel dengan ukuran bervariasi antara 1-5 cm.20 Hasil pemeriksaan fisik pada lesi kulit akan tampak gambaran central clearing, yaitu proses penyembuhan yang berada di bagian tengah lesi, sedangkan bagian tepi lesi masih aktif. Diagnosis tinea corporis dapat ditegakkan dengan pemeriksaan lampu Wood, pemeriksaan KOH dan kultur jamur. Pemeriksaan lampu Wood akan memberikan fluorosensi kehijauan. Pemeriksaan KOH dan kultur jamur pada tinea corporis menunjukkan spora atau hifa.20 Pasien pada kasus ini menunjukkan adanya gambaran central clearing pada pemeriksaan UKK, namun pada pemeriksaan lampu Wood tidak didapatkan perubahan warna, hasil pemeriksaan KOH tidak ditemukan adanya spora atau hifa, serta pada kultur jamur tidak didapatkan pertumbuhan jamur. Berdasarkan beberapa pemeriksaan tersebut diagnosis banding tinea corporis dapat disingkirkan.
Pemeriksaan biopsi histopatologi merupakan pemeriksaan baku emas yang dapat digunakan untuk membantu penegakkan diagnosis EAC.12 Gambaran histopatologi pada EAC dibagi menjadi 2 berdasarkan gambaran infiltrat limfosit perivaskular, yaitu EAC superfisial dan EAC profunda (deep). Pada EAC superfisial dapat ditemukan gambaran histopatologi berupa infiltrat limfosit perivaskular superfisial, parakeratosis fokal pada pinggiran lesi, dan spongiosis, sementara pada EAC profunda tidak terdapat perubahan epidermis, sel mononuklear perivaskular superfisial dan profunda, melanofag, sedikit vakuolisasi dan keratinosit nekrotik pada dermoepidermal junction.19 Tanda patognomonik pemeriksaan histopatologi EAC adalah gambaran coat sleeve pada infiltrat selular perivaskular dermis. Gambaran coat sleeve merupakan infiltrasi selular mononuklear yang berbatas tegas di sekitar pembuluh darah dermis.8 Pemeriksaan histopatologi pasien ini diambil dari biopsi jaringan kulit wajah, di mana pada lapisan epidermis ditemukan gambaran hiperkeratosis dan spongiosis ringan serta pada lapisan dermis ditemukan infiltrat limfositik perivaskular di sekitar pembuluh darah (coat sleeve) sesuai dengan gambaran EAC superfisial.
Tata laksana EAC tergantung pada penentuan dan penatalaksanaan kondisi yang mendasarinya.18 Tata laksana EAC mencakup pemberian antihistamine oral seperti chlorpheniramine, diphenhydramine, doxepine, acrivastine, cetirizine, atau loratadine untuk mengatasi rasa gatal yang sering dikeluhkan oleh pasien EAC. Regimen topikal meliputi antipruritus seperti calamine atau 1% menthol dan/atau corticosteroid topikal.17 Corticosteroid yang direkomendasikan pada kasus EAC anak maupun dewasa adalah corticosteroid topikal potensi kuat sebanyak dua kali sehari. Corticosteroid sistemik dapat digunakan untuk menekan perkembangan lesi EAC, namun kekambuhan seringkali terjadi setelah penghentian terapi.10 Pasien pada kasus ini diberikan terapi menggunakan cetirizine 1x10 mg dan krim mometasone 0,1% yang dioleskan dua kali sehari, disertai edukasi untuk menghindari faktor pencetus seperti aktivitas berlebih dan selalu memakai pelembap sesaat setelah mandi. Pemantauan selama satu minggu setelah pemberian terapi menunjukkan perbaikan klinis yang cukup bermakna dengan berkurangnya lesi eritematosa di wajah dan badan. Selanjutnya lesi kulit pasien semakin berkurang, kemerahan berkurang disertai rasa gatal yang berkurang setelah enam minggu kemudian.
Terapi alternatif dengan menggunakan antibiotik atau antijamur yang diberikan secara empiris dapat dipertimbangkan selain pemberian corticosteroid yang terbukti efektif pada pasien EAC.18 Penelitian Chuang, dkk. (2015) melaporkan bahwa pemberian erythromycin dengan dosis 250 mg sebanyak 4 kali sehari pada 8 orang pasien EAC selama 2 minggu menghasilkan perbaikan lesi EAC.5 Mekanisme kerja erythromycin dan azithromycin pada EAC masih belum diketahui dengan jelas, namun diperkirakan efek antiinflamasi antibiotik golongan macrolide tersebut membantu untuk mengatasi pelepasan radikal bebas, serupa dengan pemberian metronidazole.5 Pada kasus ini pasien tidak diberikan terapi antibiotik dan antijamur, namun terapi tersebut menjadi alternatif apabila setelah pemberian corticosteroid kondisi pasien tidak menunjukkan adanya perbaikan.
Penyembuhan EAC membutuhkan waktu rata-rata 11 bulan, di mana sebagian besar kasus dapat sembuh dalam waktu 3 tahun. Kim, dkk. (2016) melaporkan bahwa rata-rata waktu penyembuhan 22 orang pasien EAC superfisial adalah 4 bulan, di mana 7 orang pasien dilaporkan mengalami kekambuhan lesi. Prognosis penyakit EAC dilaporkan cukup baik, kecuali apabila berhubungan dengan keganasan atau penyakit sistemik lainnya yang mendasari. Sebanyak 50% pasien EAC menunjukkan respons yang baik terhadap pengobatan.7 Pasien pada kasus ini menunjukkan perbaikan klinis yang cukup bermakna dengan berkurangnya lesi eritematosa terutama di area wajah setelah satu minggu pertama setlah pemberian terapi. Enam minggu kemudian, lesi kulit pasien semakin berkurang, kemerahan menghilang, disertai rasa gatal yang berkurang.
RINGKASAN
Seorang anak laki-laki 9 tahun, datang ke Poliklinik Kulit dan Kelamin RSDM Surakarta dengan keluhan bercak kemerahan pada wajah dan badan. Dari hasil autoanamnesis, pemeriksaan laboratorium, dan histopatologi, pasien didiagnosis dengan erythema annulare centrifugum (EAC). Pasien mendapatkan cetirizine untuk mengatasi keluhan rasa gatal dan mometasone topikal untuk menekan perkembangan lesi. Enam minggu setelah pemberian terapi kondisi pasien menunjukkan lesi kulit yang semakin berkurang, kemerahan menghilang, disertai rasa gatal yang berkurang. Penentuan pemberian terapi pada kasus EAC ditetapkan berdasarkan dugaan penyebab yang mendasarinya sehingga dapat diberikan terapi yang sesuai. Terapi definitif kasus ini masih membutuhkan penelitian lebih lanjut.
DAFTAR PUSTAKA